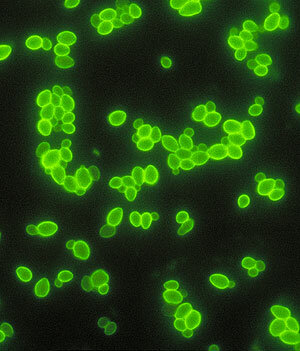
candidiasis

-
 La primera transfusión a un humano documentada es la realizada por el francés JEAN BAPTISTE DENIS, filósofo y matemático de Montpellier y médico de Luis XIV; transfunde “sangre suave y loable de animal, menos contaminada de vicios y pasiones”, y que logra transmitir las características de los seres donantes.
La primera transfusión a un humano documentada es la realizada por el francés JEAN BAPTISTE DENIS, filósofo y matemático de Montpellier y médico de Luis XIV; transfunde “sangre suave y loable de animal, menos contaminada de vicios y pasiones”, y que logra transmitir las características de los seres donantes. -
La primera observación en un diabético fue realizada por Cawley y publicada en el "London Medical Journal"
-
Charles Badham describió la bronquitis y bronquitis crónica como trastornos discapacitantes.
-
Bennett, en Edimburgo, aisló el hongo conocido hoy día como Candida albicans en el esputo de un paciente tuberculoso.
Bennett, en Edimburgo, aisló el hongo conocido hoy día como Candida albicans en el esputo de un paciente tuberculoso. -
 La primera cirugía cardíaca exitosa, realizada sin complicaciones, fue llevada a cabo por el Dr. Ludwig Rehn de Fráncfort del Meno, Alemania, quien reparó una herida de una puñalada en el ventrículo derecho
La primera cirugía cardíaca exitosa, realizada sin complicaciones, fue llevada a cabo por el Dr. Ludwig Rehn de Fráncfort del Meno, Alemania, quien reparó una herida de una puñalada en el ventrículo derecho -
 Los hongos en las uñas también se denominan «onicomicosis». Cuando el hongo infecta las áreas que están entre los dedos de los pies y la piel de estos, se llama «pie de atleta
Los hongos en las uñas también se denominan «onicomicosis». Cuando el hongo infecta las áreas que están entre los dedos de los pies y la piel de estos, se llama «pie de atleta -
El primer paso decisivo en el análisis del genoma molecular, y en gran parte de las investigaciones biológicas moleculares del medio siglo pasado, fue el descubrimiento de la estructura de doble hélice de la molécula del ADN, por Francis Crick y James Watson.
-
 Richard Doll hizo una gran investigación sobre la relación entre tabaquismo y cáncer de pulmón. Habían entrevistado a más de 700 pacientes con cáncer. Sin embargo, la reacción del mundo médico no fue inmediata.
Richard Doll hizo una gran investigación sobre la relación entre tabaquismo y cáncer de pulmón. Habían entrevistado a más de 700 pacientes con cáncer. Sin embargo, la reacción del mundo médico no fue inmediata. -
el primer trasplante humano de riñón del que se tiene noticia. Para ello utilizó como donante el riñón de un cerdo al que colocó en el brazo de un paciente con IRC (Xenoinjerto) El riñón funcionó aproximadamente una hora.
-
 El levonorgestrel fue la base de los primeros anticonceptivos orales combinados
El levonorgestrel fue la base de los primeros anticonceptivos orales combinados -
Alexander Fleming, profesor de bacteriología en el Hospital St. Mary's de Londres, descubrió la penicilina, el primer antibiótico auténtico.
-
 Moderna y Pfizer. Las empresas que comercializarán las primeras vacunas contra la COVID en Europa y Estados Unidos después de que los resultados de sus ensayos clínicos hayan demostrado una efectividad superior al 90 por ciento.
Moderna y Pfizer. Las empresas que comercializarán las primeras vacunas contra la COVID en Europa y Estados Unidos después de que los resultados de sus ensayos clínicos hayan demostrado una efectividad superior al 90 por ciento.
Plan projects on a visual timeline
Map milestones, phases, deadlines, and key events in one place so the sequence is easier to see and share. Timetoast is a timeline maker for work, school, research, and stories.




